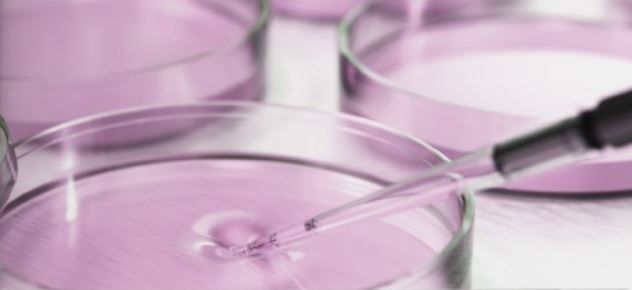

FIVE EXCITING APPLICATIONS FOR CO₂ INCUBATORS
CO₂ incubators play an important role in medical research wherever cell cultures have to be observed in as sterile and meticulous a way as possible. They keep unwanted microbes away from the cultures, thus providing the ideal conditions for growth.Different CO2 incubators offer different methods of preventing contamination in the incubation chamber.This article will tell you which product details you need to take note of to achieve the best results in various fields, such as stem cell therapy, regenerative medicine, and plastic surgery.

1. Fighting diseases using stem cell research
Progress in stem cell research is crucial for fighting diseases and especially for cancer therapy. Stem cell therapy can be used to repair or even replace dysfunctional cells and organs with tissues grown in vitro. As such, stem cell research provides the scientific foundation for regenerative medicine. When it comes to handling cell cultures, sterile conditions and maximum safety are of the utmost importance. Therefore, your CO2 incubator should also offer an automatic sterilization function. This reduces the risk of potential external contamination to an absolute minimum.
Read this case study for insights in to the progress being made in stem cells research at the Huck Institutes of the Life Sciences at Penn State University.

2. CO2 incubators incubate human skin cells for life-saving skin grafts
Regenerative medicine is one of the most promising fields of modern research. Dead tissue and damaged organs can be healed by restoring dysfunctional cells. To achieve this, skin is removed from the patient, multiplied in the CO2 incubator, and later implanted back into the patient. This new form of therapy is of ground-breaking significance for victims with extensive burns, as the significant scars which form as a result of traditional transplantation procedures can be avoided.
Human skin can only be produced with a great deal of effort and by fulfilling the strictest of safety requirements. Up to now, laboratory staff had to carry out laborious cleaning procedures before they were permitted to enter the “cleanroom” where CO2 incubators are located. However, since the demand for artificially created skin cells can barely be met, technicians started searching for a more efficient solution. They finally came up with the idea of directly integrating the CO2 incubator into the isolator. This means that laboratory staff can work in the CO2 incubator room much longer without increasing the risk of contamination.
In this case study, you can read about how this innovative method led to the creation of the “Center for the Cultivation of Human Skin.”
3. Offering stem cell therapy as a viable alternative to surgery
Regenerative medicine, in the form of stem cell therapy, has managed to revolutionize research in cardiac surgery. Stem cell therapy is now increasingly given precedence over open-heart surgery. The process can be described thus: tissue and cell clusters are grown in the CO2 incubator and implanted into the patient via cell transplantation. There are two ways of producing these stem cells:
1. The patient’s own cells are harvested, then multiplied in the CO2 incubator
2. Living tissue such as heart valves or blood vessels are grown from scratch in the CO2 incubator
The subsequent sterilization process is important when propagating stem cells in the CO2 incubator. Ideally, your CO2 incubator will feature an automatic hot air sterilization function. The sterilization cycle as a whole should meet the requirements of the European Pharmacopoeia.
In this case study, you can read all about how innovative therapies are being invented at the Center for Regenerative Medicine.

4. CO2 incubators for plastic surgery, anti-aging therapies, tissue repair, and dermatological treatments
CO2 incubators are also important tools for personalized autologous stem cell therapies. These therapies involve preparing the body's own cells for use in applications such as plastic surgery, anti-aging therapies, tissue repair, or dermatological and orthopedic treatments. Once tissue has been recovered, the stem cells are extracted and isolated from it. This comes with a risk of contamination, which is why comprehensive sterility tests are performed in the CO2 incubator, where the cell cultures will later multiply. Final genetic tests in the CO2 incubator ensure that maximum safety is achieved before the cells are implanted back into the patient.
In this case study, you can read all about how the Institute for Regenerative Medicine is making aging skin appear younger.

5. CO2 incubators for plastic surgery, anti-aging therapies, tissue repair, and dermatological treatments
The question of how to treat patients with extensive heat-related injuries presents modern medicine with several challenges. Staff at the German Institute for Cell and Tissue Replacement (DIZG) produce autologous cell cultures in order to help patients in German burn centers. These skin cell transplants, which have been grown in CO2 incubators, are used on patients when 60% of their body surface is covered by second or third degree burns. Often, regenerative medicine is the only chance for such patients to heal.
When producing or multiplying cell cultures, your CO2 incubator should have the lowest possible risk of contamination. By contrast, the fans often installed in traditional incubators, large-scale racks, and freestanding fixtures often represent a high risk of contamination, which can result in an enormous risk to the patient’s health.
In this case study, the DIZG shows how skin grafts can save lives..